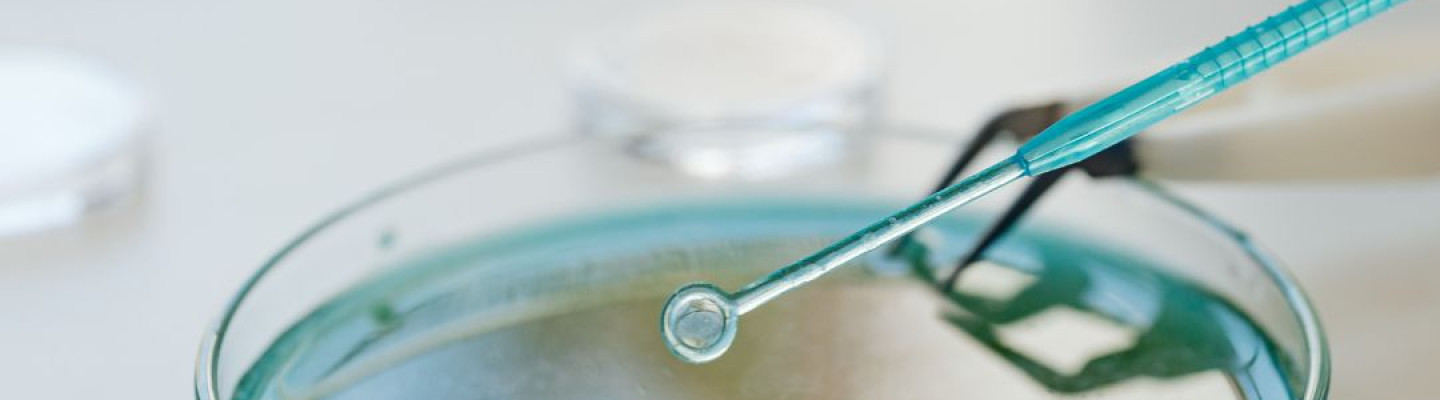
Biochemia - podstawa diagnostyki laboratoryjnej

Biochemia kliniczna, jako dyscyplina medyczna, odgrywa zasadniczą rolę w diagnostyce, leczeniu i monitorowaniu pacjentów. Jest ona odpowiedzialna za analizę i interpretację szerokiego spektrum substancji chemicznych w organizmie, które mogą dostarczyć kluczowych informacji o stanie fizjologicznym i patologicznym pacjenta. W Bionesis rozumiemy, że precyzja tych badań jest niezwykle istotna, dlatego w naszej ofercie znajdują się analizatory biochemiczne takie jak Indiko oraz Indiko Plus, które zapewniają nie tylko szybkość, ale i najwyższą dokładność wyników.
Nowoczesne analizatory biochemiczne to zaawansowane technologicznie urządzenia, które automatyzują i integrują procesy analiz biochemicznych, zwiększając tym samym efektywność pracy laboratorium. Są one wyposażone w systemy detekcji umożliwiające oznaczanie szerokiej gamy parametrów, takich jak enzymy, substraty, elektrolity, peptydy, białka oraz wiele innych markerów. Te urządzenia pozwalają na szybką analizę próbek krwi, moczu i innych płynów biologicznych, co jest niezbędne dla szybkiego rozpoznawania stanów chorobowych, monitorowania przebiegu leczenia, czy też wczesnego wykrywania potencjalnych problemów zdrowotnych.
Indiko i Indiko Plus to automatyczne analizatory biochemiczne, które reprezentują nową generację sprzętu laboratoryjnego. Ich inteligentne oprogramowanie zapewnia użytkownikom łatwą obsługę i zarządzanie procesem diagnostycznym. Systemy te są wyposażone w zaawansowane funkcje, takie jak automatyczne rozpoznawanie reagentów, kalibracja oraz kontrola jakości, co gwarantuje niezmienną dokładność wyników. Dzięki modułowej konstrukcji i możliwościom konfiguracji, Indiko i Indiko Plus mogą być dostosowane do indywidualnych potrzeb laboratorium, umożliwiając elastyczność i skalowalność w zakresie wykonywanych testów.
W Bionesis dajemy duże znaczenie nie tylko funkcjonalnościom naszych urządzeń, ale także ich niezawodności i długotrwałej wydajności. Nasze analizatory biochemiczne zostały zaprojektowane z myślą o ciągłej, intensywnej pracy, a ich trwałość i niska awaryjność to kluczowe aspekty, które przekładają się na stabilność i ciągłość procesów diagnostycznych w laboratoriach.
Dbamy o to, aby nasze produkty spełniały najwyższe standardy jakościowe. Analizatory biochemiczne z naszej oferty to wynik wieloletniej pracy i doświadczeń naszego zespołu, który nieustannie dąży do doskonalenia oferowanych technologii. Współpracując z liderami branży diagnostyki laboratoryjnej, jesteśmy w stanie zapewnić laboratoriom dostęp do najnowszych osiągnięć naukowych i najbardziej innowacyjnych rozwiązań.